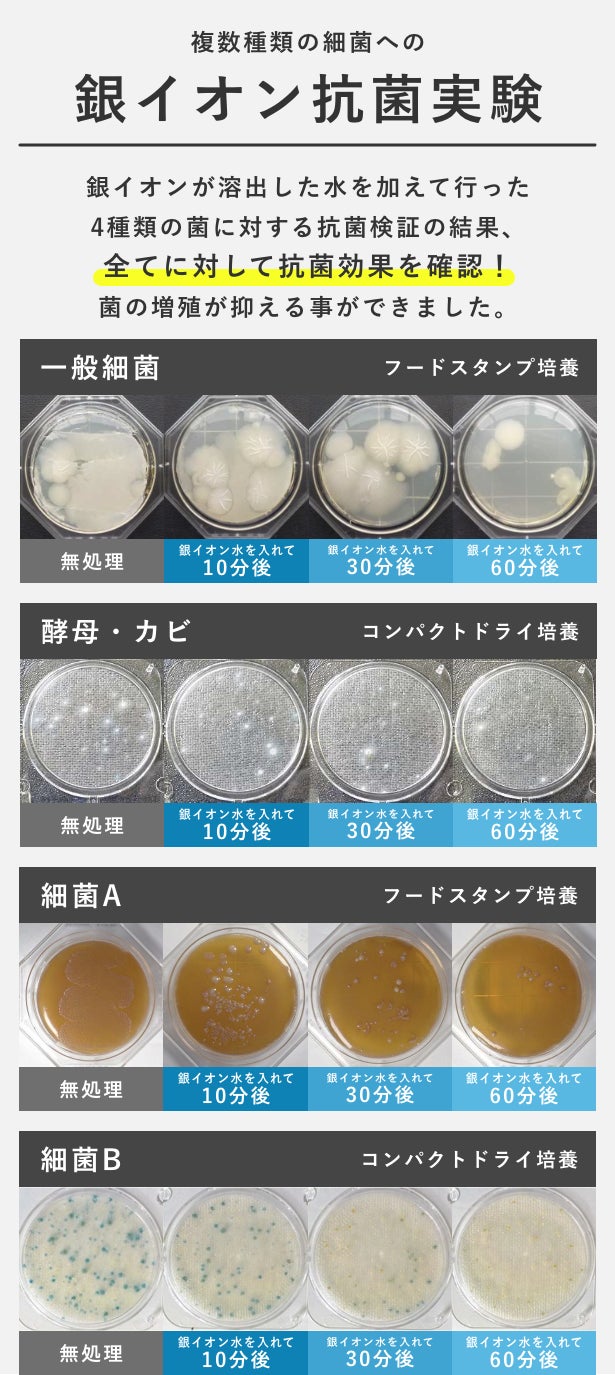

プロジェクト実行者
ストーリー
- 洗濯機にカチッと装着するだけ!工事不要の新ジャンル洗濯家電「SAWAWA AgTRY」
- アダプターが生成する銀イオン抗菌水を、ナノバブルの力で繊維の奥まで届け衣類を洗浄!
- 菌からクリアになる高次元洗浄で洗濯槽のカビまで落として、洗濯環境を丸ごとクリア!



「暮らしと水」をテーマにアイテムを展開してきたライフプロダクトブランド「SAWAWA」より、銀イオンの抗菌効果により、衣類を菌レベルで洗浄する新ジャンル洗濯家電「SAWAWA AgTRY(爽泡 エージートライ)」がMakuakeに新登場!


ホース一体型のナノバブルアダプター、またはすでにお使いのバブル系洗濯補助アイテムと一緒に使用することで、さらなる高次元洗浄を可能にするアイテムです。

毎日の洗濯で、ちゃんと洗っているのにしばらく着ていると黄ばみが出てきたり、着る前なのになんだか少し臭うような…そんな経験、ありませんか?


衣類の繊維の奥には、洗濯をしても菌や汚れの原因がしぶとく残っていて洗濯後、再び繁殖することで臭いや汚れとして現れてしまいます。

「SAWAWA AgTRY」は、
そんな洗濯の問題を
「銀イオンによる抑臭」と
「ナノバブルによる微細洗浄」
2つの力で解決。

繊維の奥まで洗剤と抗菌を届けることで、毎日の洗濯品質をアップグレードします!

「SAWAWA AgTRY」は、洗濯機のホース間に取り付けるホース一体型構造。
ワンタッチの取り付けとプラグ差し込みのみ、工具類不要で簡単セッティング!
さらにいつもと変わらない洗濯で、手軽に使用できるのがうれしいポイントです。

洗濯水がユニットパーツに流れ込む際、触媒に電気を流すことで銀イオンを発生!
それにより、洗濯水に抗菌作用を付加して菌レベルでの衣類洗浄を行うことが可能になります。

毎日の生活汚れはもちろん、「SAWAWA AgTRY」の銀イオン抗菌でニオイや黄ばみの元となる菌からクリアする洗濯をお楽しみください!

電気反応で銀イオンを発生させる「SAWAWA AgTRY」の触媒は家庭用洗濯機の通常洗濯で約1400回分以上、1日1回の洗濯で約4年分の長寿命がポイント。

洗濯1回あたりの使用金額に換算すると約20円分と非常に経済的で家計にやさしいのも大きな魅力です!
※(一般販売予定価格30,000円換算)

またカートリッジはクリアパーツで、使用と共に減っていく触媒の状態が見やすく、カートリッジを交換しながらさらに長く使用いただけます。


「SAWAWA AgTRY」による銀イオン抗菌は、ナノバブルと非常に相性よく使えるのがもう一つの大きなメリット!

「ナノバブル」とは、大きさ約0.000001mmの極めて微細、繊維よりも細かいため衣類の奥まで入り込むことが可能な泡。

「SAWAWA AgTRY」のホース一体型バブルアダプターは、そんなナノバブルを1mlあたり実に4200万個も生成して洗濯に活躍!


それにより抗菌効果が付与された洗濯水や洗剤を繊維の奥の奥まで届け、衣類の洗浄をサポートします。

銀イオンを繊維の奥まで届けるこの効果は、ホース一体型バブルアダプターに限らず、SAWAWAより販売している「SAWAWA洗濯用」やその他のバブルアダプター、ナノバブル発生機能を持つ洗濯機でも発揮!
現在お使いのバブルアダプターと合わせてご使用いただけます。


「SAWAWA AgTRY」の洗浄は、衣類に対してだけではなく洗濯槽の汚れにも効果を発揮。

洗濯槽にナノバブルが触れることで表面をクリーンにしながら、銀イオンによる抗菌でカビ・菌の繁殖を抑えることが可能!

洗うたび衣類も洗濯機もきれいに保てる「SAWAWA AgTRY」で、さらにクリーンな洗濯をお楽しみください。


ライフスタイルブランド「SAWAWA」のコンセプトは「人と水を結ぶより良い暮らし」。


これまで「シャワーアダプター」「洗濯用バルブ」「洗濯パック」「タオル」など、生活に大きく関わる水をテーマにした多くのアイテムを展開しています。

暮らしに不可欠な水と、人々がより健やかに水と付き合っていける未来を目指して、精一杯の努力をさせていただきますので、
「SAWAWA AgTRY」の応援購入をいただけますよう、何卒よろしくお願いいたします!

SAWAWA AgTRY(爽泡 エージートライ)

銀プレート(SV925)|Ag:92.5% / Cu:7.5%
本プロジェクトでは、ナノバブル系洗濯補助アイテムをお持ちの方とお持ちでない方、それぞれのためのリターンをリストアップ!


開発者について

実行者について

リスク&チャレンジ
開発中商品につき、外観デザインが変わる可能性がございます。 製品は既に製造を開始しておりますが、ご注文状況・生産状況・天候・配送問題などで、輸送が遅延する可能性がございます。 ページ中に記載させていただいた配送スケジュールは、あくまでプロジェクト公開時点の予定です。応援購入の性質上、配送遅延のおそれがございます。 原則として、配送遅延に伴う応援購入のキャンセルはできませんが、リターン配送予定月から6ヵ月を超えた場合には、希望者に限りキャンセルにて対応させていただきます。
サポーターからの応援コメント
文章のTOPへ
このプロジェクトはAll in型です。目標金額の達成に関わらず、プロジェクト終了日の2022年08月30日までに支払いを完了した時点で購入が成立します。
【超早割35%OFF】SAWAWA Ag TRY+ナノバブルホース

19,500円(税込)
超早割!【35%OFF】
商品内容:SAWAWA Ag TRY+ナノバブルホース
価格内容:一般販売予定価格30,000円(税込)から35%OFF
【注意事項】
こちらは、ナノバブルアダプターを「持っていない」方向けリターンです。
-------------------
※応援購入後のキャンセルはできません。ただし、期間中やむを得ず商品のキャンセルがあった場合、表示されている「残り個数」が変動することがございます。予めご了承ください。
-------------------
【早割30%OFF】SAWAWA Ag TRY+ナノバブルホース

21,000円(税込)
早割!【30%OFF】
商品内容:SAWAWA Ag TRY+ナノバブルホース
価格内容:一般販売予定価格30,000円(税込)から30%OFF
【注意事項】
こちらは、ナノバブルアダプターを「持っていない」方向けリターンです。
-------------------
※応援購入後のキャンセルはできません。ただし、期間中やむを得ず商品のキャンセルがあった場合、表示されている「残り個数」が変動することがございます。予めご了承ください。
-------------------
【マクアケ割25%OFF】SAWAWA Ag TRY+ナノバブルホース

22,500円(税込)
マクアケ割【25%OFF】
商品内容:SAWAWA Ag TRY+ナノバブルホース
価格内容:一般販売予定価格30,000円(税込)から25%OFF
【注意事項】
こちらは、ナノバブルアダプターを「持っていない」方向けリターンです。
-------------------
※応援購入後のキャンセルはできません。ただし、期間中やむを得ず商品のキャンセルがあった場合、表示されている「残り個数」が変動することがございます。予めご了承ください。
-------------------
【超早割35%OFF】SAWAWA Ag TRY+ノーマルホース

14,300円(税込)
超早割!【35%OFF】
商品内容:SAWAWA Ag TRY+ノーマルホース
価格内容:一般販売予定価格22,000円(税込)から35%OFF
【注意事項】
こちらは、ナノバブルアダプターを「持っている」方向けリターンです。
-------------------
※応援購入後のキャンセルはできません。ただし、期間中やむを得ず商品のキャンセルがあった場合、表示されている「残り個数」が変動することがございます。予めご了承ください。
-------------------
【早割30%OFF】SAWAWA Ag TRY+ノーマルホース

15,400円(税込)
早割!【30%OFF】
商品内容:SAWAWA Ag TRY+ノーマルホース
価格内容:一般販売予定価格22,000円(税込)から30%OFF
【注意事項】
こちらは、ナノバブルアダプターを「持っている」方向けリターンです。
-------------------
※応援購入後のキャンセルはできません。ただし、期間中やむを得ず商品のキャンセルがあった場合、表示されている「残り個数」が変動することがございます。予めご了承ください。
-------------------
【マクアケ割25%OFF】SAWAWA Ag TRY+ノーマルホース

16,500円(税込)
マクアケ割【25%OFF】
商品内容:SAWAWA Ag TRY+ノーマルホース
価格内容:一般販売予定価格22,000円(税込)から25%OFF
【注意事項】
こちらは、ナノバブルアダプターを「持っている」方向けリターンです。
-------------------
※応援購入後のキャンセルはできません。ただし、期間中やむを得ず商品のキャンセルがあった場合、表示されている「残り個数」が変動することがございます。予めご了承ください。
-------------------
【超早割35%OFF】SAWAWA Ag TRY+ナノバブルホース(2個セット)

39,000円(税込)
超早割!【35%OFF】
商品内容:SAWAWA Ag TRY+ナノバブルホース(2個セット)
価格内容:一般販売予定価格60,000円(税込)から35%OFF
【注意事項】
こちらは、ナノバブルアダプターを「持っていない」方向けのセットリターンです。
-------------------
※応援購入後のキャンセルはできません。ただし、期間中やむを得ず商品のキャンセルがあった場合、表示されている「残り個数」が変動することがございます。予めご了承ください。
-------------------
【早割30%OFF】SAWAWA Ag TRY+ナノバブルホース(2個セット)

42,000円(税込)
早割!【30%OFF】
商品内容:SAWAWA Ag TRY+ナノバブルホース(2個セット)
価格内容:一般販売予定価格60,000円(税込)から30%OFF
【注意事項】
こちらは、ナノバブルアダプターを「持っていない」方向けのセットリターンです。
-------------------
※応援購入後のキャンセルはできません。ただし、期間中やむを得ず商品のキャンセルがあった場合、表示されている「残り個数」が変動することがございます。予めご了承ください。
-------------------
【超早割40%OFF】SAWAWA Ag TRY カートリッジ

9,600円(税込)
超早割!【40%OFF】
商品内容:SAWAWA Ag TRY カートリッジ
価格内容:一般販売予定価格16,000円(税込)から40%OFF
【注意事項】
こちらは交換用のカートリッジです。
こちらのリターンのみでは、使用できません。
購入をご検討中の方は、黄色のリターン、もしくは、水色のリターンと合わせてご購入ください。
-------------------
※応援購入後のキャンセルはできません。ただし、期間中やむを得ず商品のキャンセルがあった場合、表示されている「残り個数」が変動することがございます。予めご了承ください。
-------------------
【早割35%OFF】SAWAWA Ag TRY カートリッジ

10,400円(税込)
早割!【35%OFF】
商品内容:SAWAWA Ag TRY カートリッジ
価格内容:一般販売予定価格16,000円(税込)から35%OFF
【注意事項】
こちらは交換用のカートリッジです。
こちらのリターンのみでは、使用できません。
購入をご検討中の方は、黄色のリターン、もしくは、水色のリターンと合わせてご購入ください。
-------------------
※応援購入後のキャンセルはできません。ただし、期間中やむを得ず商品のキャンセルがあった場合、表示されている「残り個数」が変動することがございます。予めご了承ください。
-------------------
「Makuake(マクアケ)」は、実行者の想いを応援購入によって実現するアタラシイものやサービスのプラットフォームです。このページは、 プロダクトカテゴリの 「ナノバブルで微細洗浄!銀イオンで抑臭!SAWAWAが、洗濯臭い抑制へ!」プロジェクト詳細ページです。












